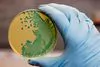
Imagem 1

产品描述
琼脂培养基作为一种文化媒体广泛用于几乎所有的致病性和非致病性细菌和真菌因为它是不容易代谢和有良好的凝胶硬度、 弹性、 清晰度和稳定性。由于其高 gellifying 电源和其蔬菜产地,琼脂培养基构成一个天然无毒矩阵形成的微生物培养基。
- 实验室用品
- 实验室化学品实验室媒体
产能:
350 M.T per annum
运输时间表:
未通知
Incoterms:
未通知包装明细:
PACKING Bulk : 25 kg fibre board drum & carton
更多关于
Marine Hydrocolloids
50-100
员工
未通知
未通知
1982
Year
成立年份
业务类型
- Industry / Manufacturer
关键词
- 琼脂培养基
- 食品配料
- 食品添加剂
- 流动
- 胶凝剂
- 琼脂琼脂制造商
- 中国草 Ver Mais
联系方式和位置
-
Kurian ********
-
+91 48********
-
Kochi / Kerala,India | 印度